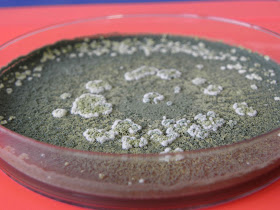

|
| A amostra inicial foi semeada em gelose chocolate, em gelose sangue e em gelose Sabouraud. Esta placa é a gelose chocolate após 7 dias de incubação. |
 |
| A amostra inicial foi semeada em gelose chocolate e em gelose sangue. Esta placa é a gelose sangue após 7 dias de incubação. |
 |
| A amostra inicial foi semeada em gelose chocolate, em gelose sangue e em gelose Sabouraud. Esta placa é a gelose sabouraud após 7 dias de incubação. |
 |
| Estirpe repicada em gelose sabouraud após 3 dias de incubação. |
 |
| Reverso da colónia. |
 |
| Estirpe repicada em gelose sabouraud após 12 dias de incubação. |
 |
| Reverso da colonia. |
 |
| Os conidióforos são ramificados e verticilados. |
 |
| As fiálides apresentam uma forma característica de frasco com gargalo alongado. |
 |
| Aglomerados de conideos presentes na ponta das phialides. |

Sem comentários:
Enviar um comentário